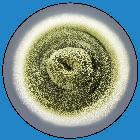

![]()






Diane Bohde has a background in both Remodeling homes for over 25 years, managing a real estate portfolio and as a Financial Planner for 15 years. She retired in 2017 from working as a Wealth Manager for High Net Worth clients to focus on changing the Indoor Air Quality Industry to be more Eco-Friendly in order to help promote a unique process that restores offices and homes to a healthier environment naturally. She and her husband, John, now focus their time on establishing new markets to further TMP’s reach and developing personnel in order to be an industry leader with a clinically-proven, all-natural approach.


John Bohde is a licensed and certified Indoor Environmental Professional (IEP) that is licensed in the states of Florida and Texas. In his time as an IEP he has assessed and remediated countless single-family homes, apartments, condos, and businesses. He has also had the pleasure of speaking at conferences such as The Mold Congress and The Mold and Mycotoxin conference as a featured presenter. During that time he presented on home assessment and bio-remediation techniques for patients and clients with environmental illnesses across the country. John has been the one to develop the assessment and remediation protocols for TMP, setting our standard for excellence throughout the company.
Josh Crowe is the Director of Operations at The Mold Pros, bringing over 20 years of extensive restoration experience to the team. In addition to his expertise in mold inspection and remediation, Josh holds certifications as a Water Damage Master Restorer, Fire & Smoke Master Restorer, and in Microbial Remediation and Contents Processing. He is deeply passionate about helping clients during their times of need, delivering expert care and support when it matters most. Outside of work, Josh enjoys quality family time with his wife and two children. You’ll often find him on the sidelines, proudly cheering them on at their sporting events.


Dr. Matt Pratt-Hyatt received his PhD in cellular and molecular biology from the University of Michigan. He has trained under Dr. Paul Hollenberg, a prominent researcher on drug metabolism and Dr. Curtis Klaassen, one of the world’s leading toxicologists. He has over a dozen publications in well-known research journals such as PNAS and Cell Metabolism. He is focused on assisting with diagnosis and treatment of mitochondrial disorders, neurological diseases, chronic immune diseases, and more. He specializes in developing tools that examine factors at the interface between genetics and toxicology. His work is bringing new insight into how genes and toxicants interact and how that may lead to mental health disorders, chronic health issues, and metabolism disorders. He is currently working with The Mold Pros as scientific advisor and interface with practitioners.


The Mold Pros began with a simple goal: Find a better way to remediate indoor environmental contaminates for those with
environmental illness.

Rather than harmful chemicals or biocides (which can be effective at killing mold, BUT often leave behind odors, VOCs, and other residues that can be harmful), we use our own natural Proprietary Bio-Enzyme Formula. It’s important to note the EPA states that even dead mold can have health concerns. The Mold Pros environmentally-friendly treatment methods biodegrade molds structure with the health of the client in mind. With no use of chorines, petroleums, or other caustic chemicals, our product is proven to be integral to our remediation process.

Our approach doesn’t require unnecessary deconstruction, saving you time and money when you use our mold remediation services.

To date, there are no federal standards established for acceptable mold levels, and only a few states have licensing requirements, so most mold remediation is unregulated. The Mold Pros developed a standard bio-remediation protocol, which adheres to and exceeds many state licensing requirements, to help ensure the same high quality standards for all mold remediation each and every time.

Here at TMP, we have an Environmental Scientist, as well as a Molecular Biologist on staff who are very knowledgeable about mold illness and environmental contaminates. Each of which is happy to consult with our clients about any test results or findings they’re concerned about.

TMP can conduct indoor air quality testing for mold, bacteria, VOCs, and allergens. We are one of the few remediation firms that test for mycotoxins (toxins produced by certain types of mold). When the mold remediation process is complete, post test sample analysis by an independent lab can be obtained to ensure that your mold problem has been resolved.


There are several situations that can cause potential environmental issues inside a structure. Here are the most common occurrences that can present suspected microbial growth.

Plumbing Leaks - Most commonly found in kitchens, bathrooms, laundry rooms, and water heaters. This is generally due to a failure in the plumbing system. Continuous leaks in plumbing are one of the more common moisture issues that lead to environmental concerns.

Water Intrusion or Storm Damage - Water intrusion can happen due to several reasons, one of them being storm damage that could compromise the integrity of the building materials. The excess of moisture due to the failure of the structure could be a chief cause of environmental problems in the damaged areas.
Improper Grading Outside - If the slope outside the house is grading toward the structure, this can cause moisture to build up around the foundation of the structure. This could lead to a water intrusion, as mentioned above.


High Relative Humidity - A high humidity inside the structure can be a cause for environmental concerns as well. The EPA recommends an indoor humidity of between 30-50 percent. This is considered normal for an indoor environment.
Natural Air Transfer - Another common cause for contaminates to be found in your home is through natural air transfer. Having open windows and doors allows for the transfer of air inside and outside of the home, allowing particulate matter to mix.





A Hydrophile (A Greek term meaning water loving) are known as water-loving or tertiary molds. These colonizers or waterdamage molds need water activity greater than 0.9 (AW=1.0) and include many of the most toxic species such as Chaetomium globosum, Memnoniella echinata, Stachybotrys chartarum, and Trichoderma. It’s important to know that these spores are often spread by water, insects and rodents. Some of these species will aerosolize and spread throughout the structure in multiple ways, including through a heating and air conditioning system. Typical signs to look for are water damage, water staining, pipe leaks and roof leaks. Water-loving molds tend to grow slower than xerophilic molds that don’t require as much moisture.
A Xerophile (A Greek term meaning dry loving) is an organism that can grow and reproduce in conditions with a low availability of water. This also means that this particular type of fungi is “xerotolerant” or tolerant of dry conditions. Buildings can be considered “new” man-made ecosystems, where - as in other environments - a limited number of fungal species will dominate, depending on the humidity and nutrient availability. It’s important to note that these fungi are able to thrive under conditions where “marked changes in humidity happen during the day. These fungi will also thrive in environments with more moisture, however, they don’t require it.

Xerophilic
Most common form of allergenic mold Grows in areas where dampness occurred
Xerophilic
Common American Household Mold Potential Mycotoxin Producer

Hydrophilic
Commonly Found in Water-Damaged Buildings Elimination of Water Source is Key to Remediation



Xerophilic
Allergenic & Type III hypersensitivity pneumonitis (Hot Tub Lung) Thrives on Indoor Materials: Textiles, Wood, Window Sills





Hydrophilic
Allergenic & Toxigenic Mold Found in Homes with Water Damage Potential Mycotoxin Producer

Xerophilic
Allergenic & Type III hypersensitivity pneumonitis (Woodman’s Lung) Potential Mycotoxin Producer

Hydrophilic
Common Allergenic & Toxigenic Mold
Thrives in damp, water damaged areas of buildings



VOCs
Ethanol - Cleaners, Alcohols, Wipes
Isopropanol - Alcohols, Cleaners, Solvents
Butane - Lighter Fluids, Gas, Aerosol Propellant
Pentane - Gasoline, Aerosol Propellant
Acetone - Nail Care, Cleaners, Paints, Adhesives
Isobutane - Fuel, Refrigerant, Lighter Fluids
Cyclohexane - Solvents, Glues, Paints
A-Pinene - Pine, Fragrances, Insecticides
Limonene - Fragrances, Paints, Cleaners
Tetrahydrofuran - Solvent, Adhesive

Aflotoxin - Aspergillus flavus, Aspergillus Parasiticus
Gliotoxin - Aspergillus fumigatus, Trichoderma, Penicillium
Ochratoxin - Penicillium cerrucosum, Aspergillus ochraceus
Trichothecine - Fusarium, Trichoderma, Stachybotrys






Here at TMP we’re often asked if the many species’ of mold have different impacts on your health. This can be categorized into two main categories: Allergenic and Toxigenic. Below we have listed out the common white molds and categorized them into both allergenic or toxigenic nature.







Mycotoxins are a poisonous substance produced by certain types of mold. These toxins are released into the environment as a way for mold to defend itself. Common molds associated with mycotoxin production are:





Aspergillus Flavus
Aspergillus Fumigatus
Aspergillus Fusarium
Aspergillus Niger
Aspergillus Ochraceus




Aspergillus Versicolor
Chaetomium Globosum
Penicillium Verrucosum
Stachybotrys Chartarum
In the extensive research done by Realtime Labs, they found that some molds are harmless to humans, but others can cause serious health issues. Mycotoxins have been linked to many types of medical issues like Chronic Fatigue Syndrome, Neurotoxicity, Immune Suppression, and many other problems. The U.S. Government has tested our food supplies for mycotoxins for years. Now, there is an increased focus on the same toxic exposures in our living environment. Click Here for more information about Mycotoxins.

If you’ve had a mold issue or someone in your home is suffering from symptoms related to mycotoxins, you may need to call a specialist to handle the problem. Many times, homeowners think they have taken care of the issue by killing the visible mold. However, they may still have mycotoxins in their home. This is because these toxins are non-living chemicals that linger long after the producing mold has been eradicated. A journal article written in 2019 by Omotayo et al states that these invisible off-gases can have a major impact on human health. Invisible to the naked eye, these particles can permeate your house through your HVAC system. They can become airborne and setting on the food you eat. When you breathe the air, the mycotoxins can work their way into your lungs. If you are to also come into dermal contact with mycotoxins, it can be absorbed through the skin. Once they have entered the body, they can pass through the bloodstream and collect in vital organs such as your liver and kidney. Not all types of mold produce mycotoxins and not all toxins cause serious health problems. Mycotoxin testing can be performed by your doctor to evaluate your symptoms. If at-home testing is required, a professional assessor is recommended.


VOC’s, also known as Volatile Organic Compounds, are chemicals that off-gas from materials such as furniture, flooring, paints, cosmetics, cleaning products and fabrics. These chemicals build up in our homes and offices and influence the health of occupants that are sensitive or have existing allergies. This problem is usually exacerbated by poor ventilation that allows odors to occur. The presence of these VOC’s can be determined through specialized testing that will enable hygienists to determine a course of action. Several studies exist that highlight the effects of VOC’s on residents, including one journal written by Sarigiannis et al that evaluates the overall risk of VOC’s in indoor environments. The EPA also recognizes the following symptoms being correlated with VOC’s.




Headaches
Metallic taste
Dizziness
Eye Irritation



Shortness of breath
Rashes
Prolonged exposure may be life threatening
Here at TMP, we offer testing using state of the art technology for a large list of Volatile Organic Compounds as well as formaldehyde. These samples are taken to test the inhalation risk inside the home. Remediation includes the relocation of the items in question to allow it to off-gas outside of the structure. The home also needs to be properly ventilated during this time along with a carbon or chemical filter to help to reduce these VOCs.



Actinomycetes are the most frequent species of bacteria found in buildings damaged by water. This is the type of bacteria that produces biotoxins similar to mycotoxins produced by mold. They have been known to contain pathogens that exacerbate hypersensitivity pneumonitis, or HP. It’s important to note that thermophilic actinomycetes and mycobacteria have been associated with decreased lung function, respiratory, or systemic symptoms reflecting granulomatous disease, otherwise known as asthma (Park et al., 2016).



Fever and Chills
Shortness of Breath on Exertion
Flu-like Achiness




Wheezing
Chest Tightness
Coughing Attacks


As one of the environmental specialists to test for actinomycetes, this DNA-sequence based test identifies 40 main species of actinomycetes that are found in building-related diseases.








Nausea
Headache
Fatigue
Asthma
Memory Loss
Irritation of the eyes, nose, skin, throat, and lungs
People who have asthma, allergies, sinusitis and other respiratory conditions can be more susceptible to complications if mold is present in the home or business. Also, people who have weakened immune systems are at greater risk for complications, including those with HIV, diabetes and infants whose immune systems are not fully developed.





Lung Disease
Kidney (renal) failure
Acute idiopathic pulmonary hemorrhage (especially infants)
Some forms of cancer, including lung and liver cancer
Increased lower respiratory illness and/or viral infections



The Mold Pros feature organic formulas that are not toxic to pets, people, plants, clothing, furniture and carpets. The product is safe both during and after application. It is effective on HVAC systems, drywall, framing, flooring, clothing and furniture.


Biotransformation
Enzymatic degradation of mycotoxins leads to non-toxic metabolites
A SurfaceGuard study was conducted by a second party lab. RealTime Labs measured mycotoxins on three different samples (figure 1). The initial values are depicted in blue, green, and orange. Following with the treatment of the SurfaceGuard for 24 hours, there were no detectable mycotoxins in any of the three samples (Hooper, 2019).

Enzyme & Botanical Based Formula No Phenolic Compounds



For over a decade, The Mold Pros have addressed concerned client’s questions regarding environmental issues. Below are a few of the most common questions. If you have additional questions, contact your local office. We are more than happy to help!
“What Causes Mold?”
Excess moisture causes mold growth. It is important to first understand the moisture source - this could be groundwater, surface leaks, plumbing leaks, roof failures, or elevated humidity. The Mold Pros whole home inspection begins with a complete moisture inspection to help identify the root cause of mold growth.
“How Much Does it Cost to Test for Mold?”
The cost to test for mold is determined by the size, layout, and samples taken inside the structure. The Mold Pros are able to determine the number and type of test that is best for your situation during a quick phone call.
“Why Should I Test for Mold?”
If you have a mold concern, The Mold Pros recommends a professional assessment. A comprehensive assessment should help identify the contaminates and levels included in the entire structure, and try to identify the moisture issues.
“What is the Difference Between Chemical Mold Treatments & TMP’s Proprietary Formula?”
Remediators use a variety of substances and methods to kill and/or remove mold. Chemicals or biocides, often with proprietary names, are capable of killing molds effectively - BUT they often leave behind odors, VOC’s and other residues that can be harmful. The Mold Pros uses an enzymatic and botanical blend to effectively address indoor fungal issues.
“Can I use bleach to kill mold?”
While bleach may kill mold on some surfaces, it is not recommended for use on porous surfaces such as wood, drywall, cloth, etc. Chlorine bleach cannot get into the porous surface where most hyphae grow and attach themselves. Bleach has an ion structure that prevents it from penetrating porous surfaces, thus the root structure inside the porous surfaces are not killed.
“How
The majority of remediations performed by The Mold Pros are completed within 1-2 days. Factors which impact the remediation are sized of the structure, the extent of the contamination and the damage.


We work with a number of practitioners across the country, all with one common goal in mind: better health for their clients. We spoke to Dr. Neil Nathan, MD - an expert in the treatment of mold and mycotoxin exposure. On the TMP website, you can find a webinar, featuring Dr. Neil Nathan. We also spoke to Dr. Matt Pratt-Hyatt, a PhD in Cellular and Molecular Biology who has worked in research and development.

Dr. Neil Nathan, MD Mold & Mycotoxin Expert

“Removing the patient from Mold & Mycotoxins is essential for effective treatment. The Mold Pros method of using enzymes to degrade toxins is the next step in helping people have healthy environments. Their inspections are extremely comprehensive, which is important to finding the underlying cause.”
Dr. Neil Nathan is a Board-Certified Family Physician and published author on healing the body from environmental illness, fatigue, and other chronic illnesses. As a Founding Diplomate of the American Board of Holistic Medicine, he decided to retire from clinical practice after almost 5 decades.
“For me, and for my patients, conventional medicine had many answers, but sometimes they weren’t enough.”
Dr. Nathan began mentoring and teaching other practitioners across the world about the importance of treating chronic illness. Since he started treating others, he has published a number of works, including “Toxic: Heal Your Body” and “Healing is Possible”. Dr. Nathan’s hope is to be able to shine a light on chronic illness and sensitivities so that healing can begin.

When talking to Dr. Matt Pratt-Hyatt, we heard about treatment and discovery more from the perspective of analysis. With a PhD in Cellular and Molecular Biology, Dr. Pratt-Hyatt has focused more on the data and functional medicine approach.
“I have been very lucky to never experience mold issues myself, but it was very surprising to me how pervasive mold illness is. When I came to The Mold Pros, I thought maybe 5% of the clients we were working with would have mold problems. However it turned out to be like 20-33%. It really is a driver of longterm illness.”
During the interview, we asked Dr. Pratt-Hyatt what he felt was the first step to remission for mold illness, he explained,
“There are may first steps that you need to take to remission. First, is to figure out there is a problem, usually through testing. Then, a person needs to find out where the exposure came from; this is done through inspection. Finally, a person needs to find a good practitioner who has experience working with patients suffering from mold exposure.”




The heating, ventilation and air conditioning system, or HVAC is the system responsible for heating and cooling your home. This system includes:





Air Conditioners
Heat Pumps
Ductwork
Thermostats
If the HVAC unit were to be compromised, this could cause a number of problems with the home’s fungal ecology. This can cause a buildup of contaminants such as mold, mycotoxins, and bacteria inside the home, causing potential illness to the occupants.





Advanced Filtration of all accessible components of HVAC
Surface treat accessible components of HVAC
Atomize with AirGuard
New high efficiency filter




Crawlspace is a water vapor buffer between the home and the earth underneath. This barrier can have a buildup of moisture, which allows for mold to grow. If not property encapsulated, it is more susceptible to microbial growth.
A crawlspace has all of the things that mold needs to thrive: oxygen, water, and complex carbon compounds (dust, pollen, airborne spores, etc.)

Full Inspection of Crawlspace
Surface Treat & Atomize Areas of Concern
Set up Dehumidifier
Remove/dispose of contaminated materials per EPA recommendations.
Vents or Intrusions are Sealed
Encapsulate Side Wall to Seal Plate
Connect Floor & Wall Sheeting
Seal around Support Pillars and Posts
Install ventilation system



Ventilation Systems are air exchange systems, some of which may or may not impact humidity, that are placed inside the basement or crawlspace of a home. This helps to regulate any excess moisture, dust, and other air contaminants inside the structure - inevitably reducing the risk of mold growth in high-moisture areas. The American Lung Association and the EPA recommend three strategies for reducing indoor air pollutants: Source Control
Crawlspace, slab foundation and Basement ventilation systems tackle all of these, creating cleaner and fresher indoor air.
Unlike other products, ventilation systems are designed to rid the home of harmful moisture and humidity - not just circulating moisture or stale air. The system creates a slight pressure variance, drawing in damp, contaminated air down and out of the home, ventilating it to the outside. This creates an air exchange that occurs up to 10 times per day, providing a much needed path of escape for airborne contaminants. Some ventilation systems are controlled by a humidity gauge that will regulate the unit based on the desired humidity and fan speed. These systems outperform dehumidifiers and air purifiers by providing healthier indoor air. It cycles the air out of the home, unlike a dehumidifier that recycles the same air through a filter. It also addresses the issue of moisture and dampness in the home, cycling that into the outside air as well.




The Mold Pros offer the installation of a few different ventilation products: The Basement Ventilation System, a Slab Foundation System, and the Crawlspace Conditioner. Each of these systems help to remove contaminates from the air in high risk areas of the home, exhausting them out of the home and into the outside air. These systems can be included in any remediation proposal upon the request of the client - ask one of our offices about our ventilation system options.


Finding the source of mold exposure is very important! A person cannot properly detoxify if they are continually exposed to environmental contaminates. Current exposure is the number one culprit. However, we could also be dealing with lingering past exposure or colonization.
When analyzing a home, The Mold pros focus on the three points that impact indoor environments.
One important number for mold inspectors to know is the water activity, or aw. aw x 100 = % relative humidity at equilibrium
The longer a material’s aw is over 0.75, the greater the risk for fungal growth. This explains why our clients in Florida, the Pacific Northwest, and Gulf of Mexico region are more likely to have mold problems - these are all high humidity areas. However, mold growth is not exclusive to humid areas. Construction and maintenance issues can also be a proponent of mold growth. These areas can be found within any part of the home/business/school. However, problems have been found in some areas more than others. In the figure below by Becher et al., you can see that a majority of problems can be localized to the basement, attic, and bathrooms. Our technicians spend as much time as necessary to do a thorough inspection in the structure. We utilize state of the art equipment to find hidden moisture behind walls and difficult to find areas. Examples of some equipment that we utilize are infrared thermal cameras, moisture meters, borescopes, and hygrometers.

When testing for microbes, there are a variety of both Direct Microscopic Exam tests as well as Polymerase Chain Reaction Tests. These include spore traps, surface samples, invasive sampling, ERMI, HERTSMI-2, endotoxins, bacterial, ATP, viral and mycotoxin tests. Each of these tests comes with a set of strengths that help us to fully identify the fungal ecology problems inside the structure.
In the case of mold, when it feels threatened, it can produce toxic metabolites. There are a few different types of toxins, each dependent on the species of mold, the environment, and the food source. The second part of the EMMA test is an environmental mycotoxin assessment. This is the only lab to perform this function, which is necessary for a full inspection. Toxins, which are molecules, are 1000 times smaller than spores, meaning they have the capacity to infiltrate areas of buildings that spores may be unable to reach. This is why the second portion of the EMMA test can provide insight to hidden fungal toxin producing colonies.


The Mold Pros believe in conducting what we call “Right-Sized” Remediations. This is based on a thorough, comprehensive inspection. This inspection provides a wide range of environmental sampling and moisture detection in order to discover the full fungal ecology of the structure. The findings allow The Mold Pros to build a remediation proposal of how best to return the home to a normal fungal ecology, getting as specific as even a partial home remediation.






Filtration that is 99.97% effective down to .3 microns.
This may not address finer particulates such as hyphal fragments and bio-mass
Can include the use of harsh, caustic chemicals such as sodium hypochlorite.
HVAC treatment in moderate & major contamination
May involve unnecessary demolition of building materials
Contaminated items stored in 6 mil poly bags
Can include expensive, outsourced content cleaning








Commercial HEPA Air Scrubbing of contaminates during demolition
Treatment of contaminated HVAC system, including ductwork
Removal/Disposal of contaminated items per EPA guidelines
Enzyme & Botaical based mold treatment
Treatment of non-porous, salvageable personal contents
Filtration that is 99.9995% effective down to .1 micron, addressing finer particulates such as hyphal fragments and biomass


The Mold Pros offers sanitizations for viral and bacterial contaminations such as actinomycetes and norovirus. The process of identifying points of bacterial contamination is accomplished by collecting surface samples. We use the ATP meter to test hot zones that can be caused by a variety of different things: Pets, Water Damage, Bathrooms, Soil Intrusion, and HVAC Contamination. Post-test sampling is conducted for efficacy and these microbial test results are shared with the client to help them understand the high risk areas for future maintenance.



Bathrooms
Kitchen



Entry Ways
Bathrooms
The Mold Pros sanitization protocol consists of using an EPA-Registered, hospital grade, botanical based solution throughout the structure. All surfaces are wiped down with this bactericidal and virucidal product and allowed to dry naturally to allow for the degradation of the bacteria. Effectiveness of bacterial treatments can be shown through real-time ATP surface sampling. Post-testing is done for the client in this sutiation to show them the high risk areas for future maintenance.


Environmental contaminates can arise inside a home for a number of reasons - moisture being the biggest reason. Elevated moisture inside the home can lead to mold, bacterial, viral, and many other issues. Water losses can occur for a number of reasons:





Frozen & Burst Pipes
Flooded Basements
Sewage Backup
Sump Pump Failure
Roof Leaks




Slab Leaks
Plumbing Overflow
HVAC Failure
Storm Damage

The Mold Pros understands the importance of quick action when it comes to water loss in a structure. As soon as you notice water intrusion, it’s imperative to contact your local TMP branch. Our responsive team will work to dry the property quickly to minimize the water damage. It’s important to understand that, under your insurance, if not mitigated immediately, this could negatively impact your coverage. The Mold Pros will document the conditions, including moisture readings and the extent of the damage to assist the client with claims. TMP uses specialized equipment to assess and remove water from the premises. Our goal is to dry the structure in an efficient and thorough manner. With the understanding of the damage a water loss can cause long term, TMP works to ensure that your water loss does not become a bigger problem for the home.


“I was recommended by my doctor to talk to The Mold Pros to get my house mold inspected, and they quickly uncovered a horrendous toxic black mold problem resulting from a leaky upstairs toilet. My doctor told me that she NEVER seen mold and mycotoxin counts as high as they were in my home. The Mold Pros were kind, respectful, took the time to answer all of my (zillion) questions, and were quick to respond to any email inquiries or phone calls I made to them. They kept to their promise of starting on our scheduled date, and ended just a few days later. They were respectful of my home and left it in good order. The third-party retest showed that no molds or mycotoxins were present. But the best news was when I had a new MRI done a few months later, and it was STABLE! I could not be happier with the exceptional work done by The Mold Pros and is immediate positive impact on my health. Thank you so much!!”
Sarah Grain, Indianapolis

This company is great, they were on the problem the same day that I contacted them, and proceeded to set up the appt. for filling the cracks and cleaning the basement. This was all done in less then two weeks, with reports sent to me explaining what was done and how it was completed. They were very professional in all aspects of the process. I would recommend them to all interested parties. We now feel completely safe and secure in our home and basement. Thank You All. Donald Appleby, Harrisonville

When we first discussed your company doing the Mold Remediation in our home, I felt sure that you and your staff would do a good job. I never thought that you and your staff would do such a terrific job. When my wife and I returned to our home after the completion of the work, we found the house in PERFECT ORDER!!!! Everything had been vacuumed, dusted , wiped clean, just a great job. The report came back from the laboratory and every item on the report was below the baseline. I was very impressed that every one of the twenty four items on the treatment plan was done to our satisfaction. After the report, the people who were interested in buying the house, wrote us a contract!! Thanks for your help and total professionalism.
Ed Sandridge, Leawood

I would highly recommend The Mold Pros. I was very impressed with the remediation process and your firm was also very timely. Everything looks great. Thank you very much! Don Petree, Lawson


As specialists in environmental concerns, The Mold Pros works with health care providers across the United States to help their patients treat the structure, while they treat the chronic illness. Practitioners understand that if their patients continue to expose themselves to a contaminated structure, they will not begin to detox from the elevations of the environmental contaminants in their body. Approximately 30% of our clients come to us without a health care provider that understands environmental illness. This is why we created our Practitioner Finder on our website. This allows our clients to find health care providers that understand environmental illness in their area. If you are looking for a practitioner or would like to join our practitioner finder, check out our website for more information.



Our Premiere Practitioner Network includes health care providers that The Mold Pros work closely with to assist their patient with environmental contamination. As a premiere practitioner, they are able to join us on monthly webinars and contribute blog content for our monthly blog posts. These providers are also labeled as a “Featured” provider on the TMP practitioner finder


R.Becher, A. H. Hoie, J. V. Bakke, S. B. Holos, J. Ovrevik, Dampness and Moisture Problems in Norwegian Homes. Int J Environ Res Public Health 14 (2017).
Delgado, A. V. (2007, January 12). Adverse Health Effects of Indoor Molds [PDF]. Boca Raton, FL: American Academy of Environmental Medicine.
Hooper, D. G. (2019, December 13). Surface Guard Efficacy Study [PDF]. Carrollton, TX: RealTime Laboratories.
Könönen, E., & Wade, W. G. (2015). Actinomyces and related organisms in human infections. Clinical Microbiology Reviews, 28(2), 419-442. doi:10.1128/cmr.00100-14
Mycotoxin urine test kit online. (2021, February 22). Retrieved March 08, 2021, from https://realtimelab.com/ product/mycotoxin-test/
Park, J., Cox-Ganser, J. M., White, S. K., Laney, A. S., Caulfield, S. M., Turner, W. A., . . . Kreiss, K. (2016). Bacteria in a water-damaged building: Associations of actinomycetes and non-tuberculous mycobacteria with respiratory health in occupants. Indoor Air, 27(1), 24-33. doi:10.1111/ina.12278
Sarigiannis, D. A., Karakitsios, S. P., Gotti, A., Liakos, I. L., & Katsoyiannis, A. (2011). Exposure to Major volatile organic compounds and Carbonyls in European indoor environments and associated health risk. Environment International, 37(4), 743-765. doi:10.1016/j.envint.2011.01.005
Volatile organic compounds’ impact on indoor air quality. (2021, February 10). Retrieved March 08, 2021, from https://www.epa.gov/indoor-air-quality-iaq/volatile-organic-compounds-impact-indoor-air-quality


Corporate Office
Florida (239) 262-6653

Midwest Region
Indiana, Illinois, Ohio, Kentucky, Tennessee, Michigan, Wisconsin, West Virginia, Pennsylvania, Vermont, Maine, Massachusetts, Rhode Island, and Connecticut (317) 622-0486

Great Plains Region

Kansas, Missouri, Nebraska, Iowa, Minnesota, North Dakota, and South Dakota (913) 871-4343
Rocky Mountain Region

Colorado, Wyoming, Montana, Utah, and New Mexico (720) 206-0129
East Coast
Georgia, Alabama, North Carolina, South Carolina, Virginia, Delaware, New Jersey, and Maryland (404) 835-0822

West Coast Region

Oregon, Idaho, Washington, Northern California, Alaska, and Hawaii (503) 755-6735
Southwest Region

Arizona, Nevada, and Southern California (602) 975-0151

Southern Region
Texas, Oklahoma, Arkansas, Mississippi, and Louisiana (469) 619-3444



